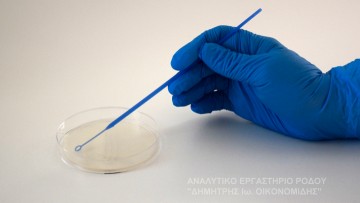
Ανίχνευση-Καταμέτρηση Λεγεονέλλας στα Δωδεκάνησα, Α’ εξάμηνο 2024

Ανίχνευση-Καταμέτρηση Λεγεονέλλας στα Δωδεκάνησα, Α’ εξάμηνο 2024
ΑΝΑΓΝΩΣΤΗΚΕ 1938 ΦΟΡΕΣ
Όπως κάθε χρόνο, το Αναλυτικό Εργαστήριο Ρόδου «Δημήτρης Ιω. Οικονομίδης», πραγματοποίησε μεγάλο αριθμό επιθεωρήσεων σε εγκαταστάσεις, ξενοδοχείων και άλλων μονάδων, στη Ρόδο και τα Δωδεκάνησα γενικά.
Για λόγους ενημέρωσης του κοινού, όσον αφορά τη Λεγεονέλλα σε εγκαταστάσεις, παρουσιάζονται τα στοιχεία των ευρημάτων των μετρήσεων που πραγματοποιήθηκαν από το Εργαστήριο, για το πρώτο εξάμηνο του 2024.
Ειδικότερα, από το Αναλυτικό Εργαστήριο Ρόδου «Δημήτρης Ιω. Οικονομίδης» αναφέρονται τα εξής:
«Στο σύνολο των σημείων που εξετάσαμε:
– 77% ήταν πλήρως απαλλαγμένα από λεγεονέλλα και
– 6% με αποικίες λιγότερες των 1000 ανά λίτρο
Τεκμηριώνοντας ότι τα συστήματα ήταν υπό έλεγχο. (83% του συνόλου)
– Σε 14% των σημείων βρέθηκαν αποικίες άνω των 1000 ανά λίτρο, ενώ σε 3% βρέθηκαν αποικίες άνω των 10000 ανά λίτρο.
Στα σημεία αυτά προτάθηκαν να γίνουν οι προβλεπόμενες διορθωτικές ενέργειες από τους διαχειριστές των εγκαταστάσεων.
Τα αποτελέσματα αυτά τεκμηριώνουν για άλλη μια φορά το υψηλό ποιοτικό επίπεδο, για το οποίο μπορούν να νιώθουν υπερήφανοι οι διαχειριστές των εγκαταστάσεων, και να αποτελούν κίνητρο για την τήρηση της ποιότητας και του επαγγελματισμού, με τον οποίο λειτουργούν μέχρι σήμερα.
Οι ελαφρώς αυξημένες ανιχνεύσεις άνω της νομοθετικής παραμετρικής τιμής, προέκυψαν λόγω της επιθυμίας των διαχειριστών των εγκαταστάσεων να προχωρήσουν σε λεπτομερέστερο έλεγχο των εγκαταστάσεών τους, ώστε και να παρέχουν μεγαλύτερη εξασφάλιση στους πελάτες τους.
Το Αναλυτικό Εργαστήριο Ρόδου «Δημήτρης Ιω. Οικονομίδης» με συνέπεια και αξιοπιστία, εξακολουθεί να πρωτοπορεί στις προσπάθειες που γίνονται για την διατήρηση του τουρισμού σε επίζηλη θέση και τεκμηριώνοντας αυτή την πρωτοκαθεδρία.
Είμαστε στη διάθεση των ενδιαφερομένων για τη διαχείριση της λεγεονέλλας στην κτηριακή τους εγκατάσταση, συμβουλευτικά, διενεργώντας εκτίμηση κινδύνου και κατάρτιση του απαραίτητου πλάνου διαχείρισης, εγκαθιστώντας συστήματα ελέγχου και παρακολούθησης για τα κρίσιμα σημεία της εγκατάστασης και φυσικά τεκμηριώνοντας το αποτέλεσμα με την εργαστηριακή εξέταση».

Ακολουθήστε τη Ροδιακή στο Google News
Ακολουθήστε τη Ροδιακή στο Google News













